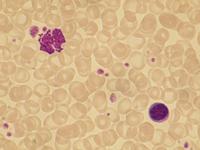

|
 |
Basophilie |
|
|
Basophilie
Autor/en: F.-G. Hagmann
Institution/en: Karlsruhe
Serie zuletzt geändert am: 28.03.2011
Basophile Granulozyten sind durchschnittlich etwas kleiner als neutrophile. Die Granulation kann in den Zellen quantitativ und qualitativ unterschiedlich ausfallen, abhängig von färbetechnischen Gegebenheiten, vom funktionellen Zustand der Zelle sowie unter pathologischen Bedingungen. Zellen mit verminderter Granulation können bei der Auszählung falsch eingeordnet werden.
Eine Vermehrung der Basophilen wird im Rahmen von hämatologischen Neoplasien bei den myeloproliferativen Neoplasien beobachtet (CML u.a., in vielen Fällen gemeinsam mit einer Eosinophilie), es gibt aber auch akute myeloische Leukämien mit Vermehrung von Basophilen. Chronische Basophilenleukämien sind selten.
Reaktiv können die Basophilen (normal 0-1% bei normalen Granulozyten und Leukozyten) vermehrt sein bei allergischen Zuständen, Parasitosen, Infektionen, Malignomen, chronisch entzündlichen und endokrinen Erkrankungen (Anstieg der basophilen Granulozyten auf über 50 bis 150/µl). Beispiele: Myxödem, Hyperlipämie, Tuberkulose, Varizellen und Variola. Bei Allergien und Parasitosen steht größtenteils eine Eosinophilie im Vordergrund, die inkonstant mit einer Basophilie (als Nebenbefund) vergesellschaftet sein kann. In den meisten Fällen besitzt die reaktive Basophilie keinen entscheidenden diagnostischen Wert.
Bei Leukozytenkonzentration mit der Zytozentrifuge sollte eine erhöhte Basophilenzahl im Ausstrich kontrolliert werden, da man unter diesen Umständen häufig eine relative Vermehrung sieht. Gewebsbasophile (Mastzellen) kommen im Blut so gut wie nicht vor.
Literaturreferenzen:
-
Begemann H, Rastetter J. Klinische Hämatologie. 4. Auflage. Georg Thieme Verlag, Stuttgart - New York 1993
[DNB]
-
Davies S, Bain BJ. Basophil counts on the technicon H 1 automated counter. Clin Lab Haematol 1996;18:298-9. PMID:9054708
[Medline]
-
Queißer W (Hrsg.). Das Knochenmark: Morphologie, Funktion, Diagnostik. Georg Thieme Verlag, Stuttgart 1978
[DNB]
-
Grabener E. Blutbasophilie bei Hyperlipidämie. Med Klin 1975;70:510-5. PMID:48182
[Medline]
-
Devouassoux G. Le polynucléaire basophile, clé de la réaction allergique - Modulations par les chimiokines. Rev Mal Respir 2000;17:629-40. PMID:10951958
[Medline]
-
Lennert K, Parwaresch MR. Die Reaktion der basophilen Granulozyten auf eine postprandiale Hyperlipämie. Schweiz Med Wochenschr 1970;100:1410-5. PMID:4111179
[Medline]
-
Zöllner H. Beziehungen zwischen Serumlipiden und basophilen Leukozyten im Blut beim gesunden Säugling während der alimentären Hyperlipämie. Folia Haematol Int Mag Klin Morphol Blutforsch 1968;90:394-400. PMID:4179824
[Medline]
-
Petrasch SG, et al.: Basophilic leukocytes in hypothyroidism. Clin Investig. 1993 Jan;71(1):27-30. PMID:7680925
[Medline]
-
Bernard J, et al. Hématologie. Flammarion Medecine-Sciences, Paris 1976
-
Ohnmacht C. Die Bedeutung von angeborenen Effektorzellen während einer Typ 2 Immunantwort - Funktionelle Charakterisierung von eosinophilen und basophilen Granulozyten. Dissertation der Fakultät für Biologie der Ludwig-Maximilians-Universität, München 2009
[DNB]
|

 Zum Seitenanfang Zum Seitenanfang
 Sitemap
| Sitemap
|  |
| 
|
|